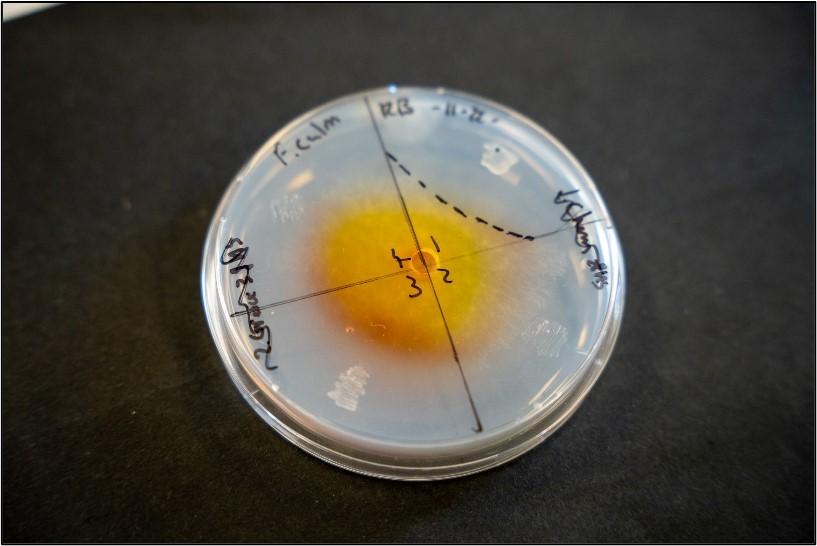
2

EnzymeCP: enzyme compositions as the future of biological plant protection

 Project title
Project title
EnzymeCP: enzyme compositions as the future of biological plant protection
 Name of Beneficiary/Beneficiaries
Name of Beneficiary/Beneficiaries
BioMosae B.V. – Netherlands (Consortium Leader)
Dekota a.s. – Czech Republic (Consortium Member)
RDLS Sp. z o.o. – Poland (Consortium Member)
 Name of programme
Name of programme
International programmes
 Competition
Competition
Eurostars
 Project value
Project value
PLN 4,609,320.00
 Funding value
Funding value
PLN 2,765,592.00
 Project delivery period
Project delivery period
from 1 June 2020 to 31 May 2023
See the results of our work
Photo 1. Laboratory production of the biopesticide
Photo 2. Antifungal action of the biopesticide
Photo 3. Verification of biopesticide efficacy in greenhouse tests
What problem does our project solve?
The use of pesticides in modern agriculture has become not only essential, but also difficult to replace. While chemical pesticides are highly effective, increasing amounts of literature point to their significant harmful effects on plants, consumers, and the environment. Recently, numerous studies have aimed to develop effective alternatives to chemical pesticides that retain high efficacy against phytopathogens while being environmentally friendly and cost-effective to produce. Biological products with fungicidal and/or fungistatic properties appear to be a valuable alternative to traditional pesticides. Among such substances are lytic enzymes produced by various microorganisms, including many bacterial species. One group of enzymes that are effective against phytopathogens are chitinases, which play an active role in degrading chitin, the primary component of fungal cell walls and the exoskeletons of insects that infect plants. The goal of the project was to develop an innovative biopesticide based on bacterial enzymes, specifically chitinases. Polyurethane foams impregnated with chitin were used as inducers for the extracellular production of chitinases by the selected bacterial strain.
Who will benefit from the project's results?
The solution developed as part of the project is intended for professional agriculture, horticulture and fruit farming, as well as for enthusiasts of amateur home plant cultivation, both for crops and ornamental plants. These are also the end users of the developed solution. The enzymatic microbial preparation with phytopathogen inhibition properties offers a valuable alternative to traditional plant protection products used in both agriculture and horticulture, in Poland and internationally.